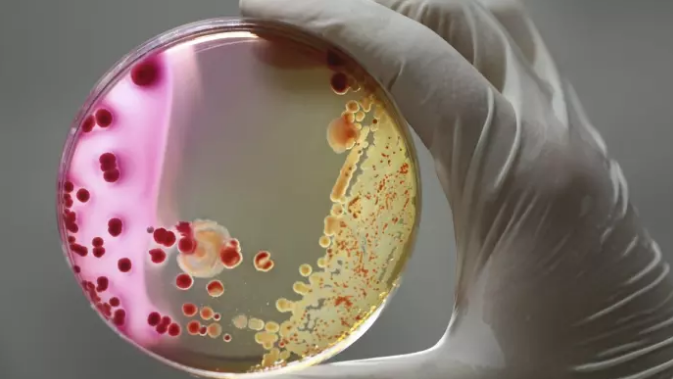

靶向药百科
*以上解读内容仅供参考,癌症123不对解读内容负责。
印度帕唑帕尼公认价格实惠
2017-04-18印度市场销售的帕唑帕尼仍然是GSK出品的帕唑帕尼,要能是市场或专利问题,印度本地并没有哪家药企有推出仿制帕唑帕尼,因此印度帕唑帕尼与GSK在其它市场的帕唑帕尼并无差别。
唑帕尼治疗晚期软组织肉瘤
2017-04-18在2014年4月26日,美国食品与药物管理局(FDA)批准Votrient(帕唑帕尼)用于既往接受化疗的晚期软组织肉瘤患者。软组织肉瘤是一种源于肌肉、脂肪、纤维组织和其他组织的恶性肿
“药滞”中国为什么不能有印度阿比特龙特效药?
2017-04-14因为中国的新药进口特别的慢,行业内形容这种现象有个词叫做“药滞”,今天就来谈谈中国的药滞是怎么造成的。
过一段时间,美国又研发出来哪中国抗癌靶向新药
过一段时间,美国又研发出来哪中国抗癌靶向新药
Zytiga阿比特龙是怎么起到作用的?
2017-04-14Zytiga(醋酸阿比特龙)是一种为肾上腺抑制激素疗法。它是在结合使用泼尼松治疗那些已经接受过化疗的转移性去势抵抗性前列腺癌含多西紫杉醇(多西他赛)。
美国詹森生物技
美国詹森生物技
阿比特龙(Zytiga)用于治疗晚期前列腺癌
2017-04-14美国食品和药物管理局批准Zytiga(醋酸阿比特龙)已经扩大到包括治疗晚期阉割抗性前列腺癌,在化疗前则可服用。
该药物旨在减少男性性激素睾酮的产生,于2011年11月首次获
该药物旨在减少男性性激素睾酮的产生,于2011年11月首次获
阿比特龙(ZYTIGA)如何服用?
2017-04-14推荐剂量:ZYTIGA 是口服给予1,000 mg每天1次与泼尼松5 mg口服给药每天2次联用。ZYTIGA必须空胃给药。服用ZYTIGA前至少2小时和服用ZYTIGA后至少1小时不应消耗食物。应与
转移性去势抵抗性前列腺癌交给阿比特龙+多西他赛来治
2017-04-14转移性去势抵抗性前列腺癌(mCRPC)的治疗是泌尿外科和肿瘤科常见的难题。
一项由 Tagawa 教授等完成的联合应用阿比特龙和多西他赛及泼尼松治疗 mCRPC 的 1b 期临床研
一项由 Tagawa 教授等完成的联合应用阿比特龙和多西他赛及泼尼松治疗 mCRPC 的 1b 期临床研
阿比特龙(ZYTIGA)治疗的肝毒性
2017-04-14对治疗用阿比特龙ZYTIGA期间发生肝毒性患者(ALT和/或AST大于5 × ULN或总胆红素大于3 × ULN),中断阿比特龙ZYTIGA治疗[见警告和注意事项]。在肝功能检验返回
怎么用醋酸阿比特龙片
2017-04-14醋酸阿比特龙片已经投入临床治疗多时,治疗效果显著,有很多患者都在使用卡铂注射液 ,得到不少患者的好评,这是一种效果良好的药物。但是一些患者对于醋酸阿比特龙片的用法用
能空腹服用阿比特龙吗?
2017-04-14注意:阿比特龙必须空胃服用。
阿比特龙厂家在服用阿比特龙剂量前至少2小时和服用阿比特龙剂量后至少1小时不应消耗食物。
当单剂量醋酸阿比特龙与餐给予与
辉瑞和Astellas公司在晚期癌症试验阿比特龙【Zytiga】失败
2017-04-14美国制药巨头辉瑞和日本Astellas宣布用阿比特龙【Zytiga】治疗晚期癌症的Xtandi(enzalutamide)试验以失败告终。
一项晚期试验发现,除了Zytiga和类固醇方案之外,辉瑞公
阿比特龙获批成为前列腺癌新药
2017-04-142011年4月,FDA批准阿比特龙用于docetaxel(多西他赛,一种化疗药)治疗后前列腺癌依然恶化的患者其。阿比特龙可减少男性激素睾丸酮的生产。
罹患前列腺癌时,睾丸酮刺激前列腺
罹患前列腺癌时,睾丸酮刺激前列腺
阿比特龙是晚期前列腺癌患者的有效治疗药物
2017-04-14晚期前列腺癌的药物可能在英国和威尔士被批准用于NHS使用,医疗监督机构扭转了早先的决定。
阿比特龙,每月费用约3,000英镑,可延长使用寿命三个月以上,最初被英国NICE机
阿比特龙,每月费用约3,000英镑,可延长使用寿命三个月以上,最初被英国NICE机
阿比特龙显著延长ERG突变的前列腺癌患者的寿命
2017-04-14根据最近的两项研究,阿比特龙是一种用于前列腺癌治疗的药物,发现在化疗前给予晚期前列腺癌患者服用可大大提高其生存率。
以前的研究发现,在CVD降低癌症进展时间之前服
以前的研究发现,在CVD降低癌症进展时间之前服
低脂饮食配合阿比特龙治疗前列腺癌
2017-04-14前列腺癌广泛使用的药物醋酸阿比特龙在早餐低脂饮食情况下给予1/4推荐剂量与空腹给予标准推荐剂量相比疗效相同,但是价格上要便宜四倍。
这一发现具有重大的临床经济
这一发现具有重大的临床经济
阿比特龙治疗转移性前列腺癌效果显著
2017-04-14根据一项新的研究,醋酸阿比特龙治疗在化疗初期治疗转移性原前列腺癌患者中延长了4.4个月的存活期。
研究人员随机分配了1,088例无症状或轻度症状化疗患者,接受醋酸泼
研究人员随机分配了1,088例无症状或轻度症状化疗患者,接受醋酸泼
低脂肪膳食可能减少阿比特龙[Zytiga]等癌症药物成本
2017-04-14一项新的研究表明,当服用昂贵的前列腺癌药物时可以多加考虑一下,因为吃低脂肪餐可以将药物的成本降低四分之三。
芝加哥大学医学助理教授Russell Szmulewitz博士说:&ld
芝加哥大学医学助理教授Russell Szmulewitz博士说:&ld
晚期前列腺癌对联合免疫治疗反应良好
2017-04-14晚期前列腺癌患者对免疫检查点阻断和针对某些免疫阻断细胞的治疗的组合反应良好。这些晚期前列腺癌对称为雄激素剥夺治疗(ADT)的化学阉割治疗有抗性,并且它们经常复发并进
强生公司的的阿比特龙
2017-04-14欧洲药品监管机构继 FDA 之后,批准了强生公司前列腺癌药物阿比特龙的新适应症。
强生公司旗下的扬森齐拉格机构宣布欧盟委员会已批准了阿比特龙(乙酸阿比特龙酯)的新适
强生公司旗下的扬森齐拉格机构宣布欧盟委员会已批准了阿比特龙(乙酸阿比特龙酯)的新适
阿斯利康制药公司快速跟踪Tagrisso辅助诊断
2017-04-13制药公司接受较低的销售,因为他们转向个性化治疗。
美国监管机构上个月向阿斯利康公司提供了一个新的肺癌治疗绿灯,标志着创纪录的最快的药物批准之一。 这个过程有时
美国监管机构上个月向阿斯利康公司提供了一个新的肺癌治疗绿灯,标志着创纪录的最快的药物批准之一。 这个过程有时
正版AZD9291价格?
2017-04-13Osimertinib(商品名:Tagrisso,塔格瑞斯)基本情况
AZD9291,也叫Osimertinib,由英国阿斯利康生产,Tagrisso是一种口服的小分子第三代表皮生长因子酪氨酸激酶抑制剂(EGFR-TKI)
AZD9291,也叫Osimertinib,由英国阿斯利康生产,Tagrisso是一种口服的小分子第三代表皮生长因子酪氨酸激酶抑制剂(EGFR-TKI)